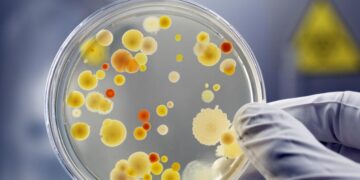
It's official—scientists have revived bacteria from 5,000 years ago and believe it could help fight superbugs—it could combat superbugs, and the risk is concerning

It’s official—researchers in Antarctica explain the Blood Falls phenomenon, and the University of Alaska reveals what turns the ice red
In Antarctica, there’s a natural phenomenon that, for more than a century, has surprised scientists and explorers: an intense red ...
Read more